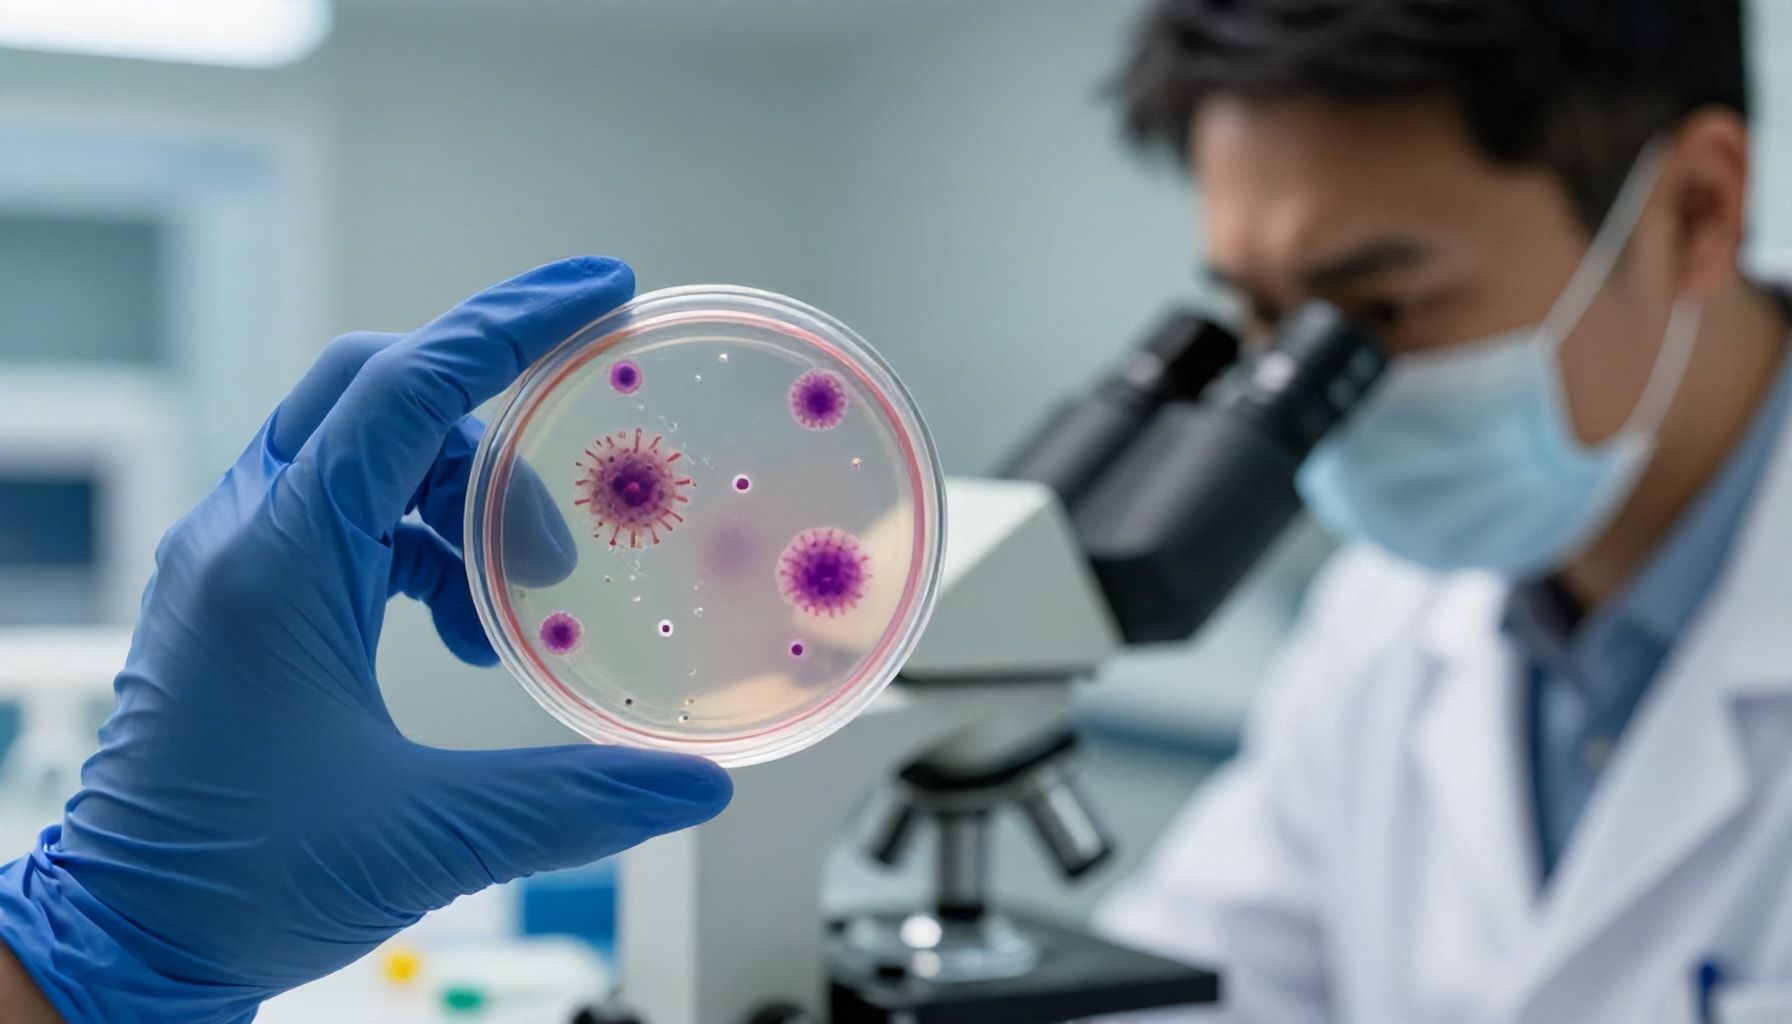
Perspectivas futuras en el manejo del herpes

El herpes en la piel afecta a más de 3.7 mil millones de personas en todo el mundo, según la Organización Mundial de la Salud. En América Latina, esta condición viral sigue siendo un desafío común en consultorios médicos, impactando la calidad de vida de quienes la padecen. Desde brotes leves hasta complicaciones más serias, entender las causas, síntomas y opciones de tratamiento del herpes en la piel es crucial para una gestión efectiva. Este padecimiento, que puede manifestarse en diversas formas, requiere atención tanto médica como preventiva. A continuación, se presenta una guía integral que aborda los aspectos clave del herpes en la piel, proporcionando información clara y práctica para quienes buscan respuestas sobre esta condición.
Qué es el herpes en la piel

El herpes en la piel es una infección viral común que afecta a millones de personas en todo el mundo. Causada principalmente por el virus del herpes simple (VHS), esta condición se manifiesta como ampollas dolorosas y grupos de llagas en la piel. Según la Organización Mundial de la Salud (OMS), aproximadamente el 67% de la población menor de 50 años tiene el virus del herpes simple de tipo 1 (VHS-1), que puede causar herpes labial y, en algunos casos, herpes genital.
Los síntomas del herpes en la piel varían, pero generalmente incluyen ampollas llenas de líquido, enrojecimiento, picazón y dolor en la zona afectada. Estas llagas suelen aparecer en los labios, la cara, los genitales o, en casos menos comunes, en otras partes del cuerpo. Según la Dra. María González, especialista en dermatología de la Universidad de Buenos Aires, «el herpes puede ser recurrente, especialmente bajo estrés o exposición al sol, y es altamente contagioso durante los brotes activos».
El tratamiento del herpes en la piel se centra en aliviar los síntomas y acelerar la curación. Los antivirales como el aciclovir, valaciclovir y famciclovir son comunes. Además, medidas como mantener la zona limpia, aplicar compresas frías y evitar el contacto con otras personas pueden ayudar a manejar la infección. En América Latina, donde el acceso a la atención médica varía, es crucial educar a la población sobre la prevención y el tratamiento oportuno para controlar la propagación del virus.
La prevención es clave. Usar protección durante las relaciones sexuales, evitar compartir utensilios personales y lavarse las manos regularmente pueden reducir el riesgo de contagio. En países como Brasil, México y Colombia, campañas de salud pública han destacado la importancia de la conciencia sobre el herpes y otras infecciones de transmisión sexual. Aunque no hay cura, un diagnóstico temprano y un tratamiento adecuado pueden mejorar significativamente la calidad de vida de quienes lo padecen.
Causas comunes de esta infección viral

El herpes en la piel es una infección viral causada principalmente por el virus del herpes simple tipo 1 (VHS-1) y, en menor medida, por el tipo 2 (VHS-2). Según la Organización Mundial de la Salud (OMS), aproximadamente el 67% de la población mundial menor de 50 años tiene VHS-1. En América Latina, esta prevalencia varía, pero se estima que afecta a una parte significativa de la población, especialmente en países con condiciones de vida precarias.
El contagio ocurre principalmente a través del contacto directo con lesiones activas, como ampollas o úlceras, o por contacto con secreciones infectadas. En el contexto latinoamericano, donde el contacto físico es común en celebraciones y rituales culturales, el riesgo de transmisión aumenta. Por ejemplo, en festividades como el Carnaval de Río de Janeiro o las Fiestas Patrias en México, el contacto cercano puede facilitar la propagación del virus.
Otras causas comunes incluyen el estrés, la exposición al sol excesiva y sistemas inmunitarios debilitados. «El estrés es un factor desencadenante importante, ya que debilita las defensas del organismo, permitiendo que el virus se active», explica la Dra. María González, especialista en dermatología de la Universidad de Buenos Aires. En países con altos niveles de estrés laboral, como Argentina y Chile, esto se convierte en un problema relevante.
El herpes labial, una de las manifestaciones más comunes, aparece como ampollas dolorosas en los labios o alrededor de la boca. En casos más graves, puede afectar otras áreas de la piel, causando malestar y complicaciones. La prevención incluye evitar el contacto con personas infectadas, mantener una buena higiene y fortalecer el sistema inmunológico. En América Latina, donde el acceso a la salud no siempre es equitativo, la educación sobre estas medidas es crucial para reducir la incidencia de la infección.
Síntomas que no debes ignorar

El herpes en la piel es una infección viral común que afecta a millones de personas en América Latina. Causado principalmente por el virus del herpes simple (VHS), puede manifestarse en diferentes formas, siendo el herpes labial y el herpes genital los más conocidos. Sin embargo, el herpes también puede aparecer en otras áreas de la piel, causando molestias y complicaciones si no se trata adecuadamente.
Los síntomas del herpes en la piel suelen incluir ampollas dolorosas que pueden romperse y formar costras. Estas lesiones aparecen en brotes, acompañadas de enrojecimiento, picazón y, en algunos casos, fiebre y ganglios linfáticos inflamados. Según la Organización Panamericana de la Salud (OPS), el herpes labial afecta a aproximadamente el 67% de la población mundial menor de 50 años, con una alta prevalencia en la región latinoamericana.
El tratamiento del herpes en la piel se centra en aliviar los síntomas y acelerar la curación. Los antivirales como el aciclovir son comunes, pero también se recomiendan medidas de cuidado personal, como mantener la zona afectada limpia y seca, evitar el contacto con otras personas y usar ropa holgada. La Dra. María González, especialista en dermatología, advierte: «La prevención es clave. Evitar el estrés, mantener una dieta equilibrada y protegerse del sol pueden reducir la frecuencia de los brotes.»
En casos graves o recurrentes, es fundamental consultar a un médico para recibir un diagnóstico preciso y un plan de tratamiento personalizado. La educación sobre el herpes y sus síntomas es esencial para prevenir su propagación y mejorar la calidad de vida de quienes lo padecen.
Tratamientos efectivos disponibles

El herpes en la piel es una infección viral común que afecta a millones de personas en América Latina y el mundo. Causada principalmente por el virus del herpes simple tipo 1 (VHS-1) y tipo 2 (VHS-2), esta condición se manifiesta a través de ampollas dolorosas que pueden aparecer en diversas partes del cuerpo. Según la Organización Panamericana de la Salud (OPS), aproximadamente el 67% de la población menor de 50 años en la región ha sido diagnosticada con herpes labial, la forma más común de esta infección.
Los síntomas del herpes en la piel varían según el tipo de virus y la ubicación de las lesiones. En el caso del herpes labial, las ampollas suelen aparecer en los labios y alrededor de la boca, causando dolor, picazón y, en algunos casos, fiebre. El herpes genital, por otro lado, se manifiesta en la zona genital y puede provocar ampollas, úlceras y dolor al orinar. «La prevención es clave en el manejo del herpes», afirma la Dra. María González, especialista en dermatología de la Universidad de Buenos Aires. «El uso de preservativos y evitar el contacto directo con las lesiones son medidas efectivas para reducir el riesgo de transmisión».
Aunque no existe una cura definitiva para el herpes, existen tratamientos efectivos que pueden aliviar los síntomas y acelerar la curación. Los antivirales como el aciclovir, valaciclovir y famciclovir son los más utilizados. Estos medicamentos, disponibles en farmacias de toda la región, reducen la duración y la gravedad de los brotes. Además, el cuidado de la piel con cremas hidratantes y el uso de protector solar pueden ayudar a prevenir la aparición de nuevas lesiones. En casos graves, se recomienda consultar a un dermatólogo para recibir un tratamiento personalizado.
En América Latina, el acceso a la atención médica varía significativamente entre países. Mientras que en naciones como Argentina, Chile y Costa Rica los tratamientos son ampliamente disponibles, en otras regiones la falta de recursos puede dificultar el acceso a medicamentos y consultas especializadas. Organizaciones como la OPS trabajan para mejorar la atención de enfermedades de transmisión sexual, incluyendo el herpes, en toda la región. La educación y la concienciación son fundamentales para reducir el estigma y promover un manejo adecuado de esta condición.
Consejos para prevenir brotes

El herpes en la piel es una infección viral común que afecta a millones de personas en América Latina. Causada principalmente por el virus del herpes simple (VHS), esta condición se manifiesta como ampollas dolorosas en la piel, generalmente alrededor de la boca o en la zona genital. Según la Organización Panamericana de la Salud (OPS), aproximadamente el 67% de la población mundial menor de 50 años tiene el virus del herpes simple de tipo 1. En la región, la incidencia varía, pero el virus es prevalente en todos los países.
Los síntomas del herpes en la piel incluyen ampollas llenas de líquido, enrojecimiento, dolor y picazón. En algunos casos, las personas pueden experimentar fiebre, ganglios linfáticos inflamados y malestar general. La Dra. María González, especialista en dermatología de la Universidad de Buenos Aires, explica que «el herpes puede ser recurrente, especialmente en personas con sistemas inmunitarios debilitados». Es crucial reconocer los primeros signos para iniciar el tratamiento a tiempo y prevenir brotes severos.
El tratamiento del herpes en la piel suele incluir medicamentos antivirales como el aciclovir, valaciclovir o famciclovir, que ayudan a reducir la duración y la gravedad de los brotes. Además, mantener una buena higiene, evitar el estrés y fortalecer el sistema inmunológico con una dieta balanceada pueden ser medidas preventivas efectivas. En países como Brasil y México, donde el acceso a la atención médica puede ser limitado en áreas rurales, la educación sobre la prevención del herpes es fundamental. Programas de salud pública en estos países han implementado campañas para concienciar sobre las medidas de prevención y el tratamiento oportuno.
Perspectivas futuras en el manejo del herpes
El herpes en la piel es una infección viral común que afecta a millones de personas en América Latina y el mundo. Causada principalmente por el virus del herpes simple tipo 1 (VHS-1) y, en menor medida, por el tipo 2 (VHS-2), esta condición se manifiesta como ampollas dolorosas en la piel. Según la Organización Mundial de la Salud (OMS), aproximadamente el 67% de la población mundial menor de 50 años tiene VHS-1, lo que subraya la prevalencia de este virus en la región.
Los síntomas del herpes cutáneo incluyen ampollas agrupadas, enrojecimiento, picazón y dolor en la zona afectada. Estas lesiones suelen aparecer en los labios, aunque también pueden manifestarse en otras áreas de la piel. En América Latina, el clima cálido y húmedo puede favorecer la proliferación del virus, especialmente en zonas costeras y tropicales. La Dra. María González, especialista en dermatología de la Universidad de Buenos Aires, señala que «el estrés, la exposición al sol y los sistemas inmunitarios debilitados son factores que pueden desencadenar brotes de herpes».
El tratamiento del herpes en la piel se centra en aliviar los síntomas y acelerar la curación. Los antivirales como el aciclovir, valaciclovir y famciclovir son los más utilizados. Además, se recomienda mantener la zona afectada limpia y seca, aplicar compresas frías y evitar el contacto con otras personas para prevenir la transmisión. En países como Brasil y México, donde el acceso a la atención médica puede ser limitado en áreas rurales, la educación sobre prevención y manejo del herpes es crucial.
En el futuro, las perspectivas para el manejo del herpes en la piel incluyen el desarrollo de vacunas más efectivas y terapias génicas. La investigación en América Latina está avanzando, con estudios en curso en instituciones como la Universidad Nacional Autónoma de México (UNAM) y la Universidad de São Paulo. Estos avances podrían reducir la incidencia y gravedad del herpes, mejorando la calidad de vida de millones de personas en la región.
El herpes en la piel es una condición manejable cuando se identifican sus causas y síntomas a tiempo. Con tratamientos adecuados y hábitos de prevención, es posible reducir su impacto en la calidad de vida. Ante cualquier sospecha, lo más importante es consultar a un dermatólogo para un diagnóstico preciso y un plan de tratamiento personalizado. En América Latina, donde el acceso a la salud sigue siendo un desafío en muchas comunidades, la educación sobre esta condición puede marcar una diferencia significativa en la detección temprana y el manejo efectivo del herpes cutáneo.

